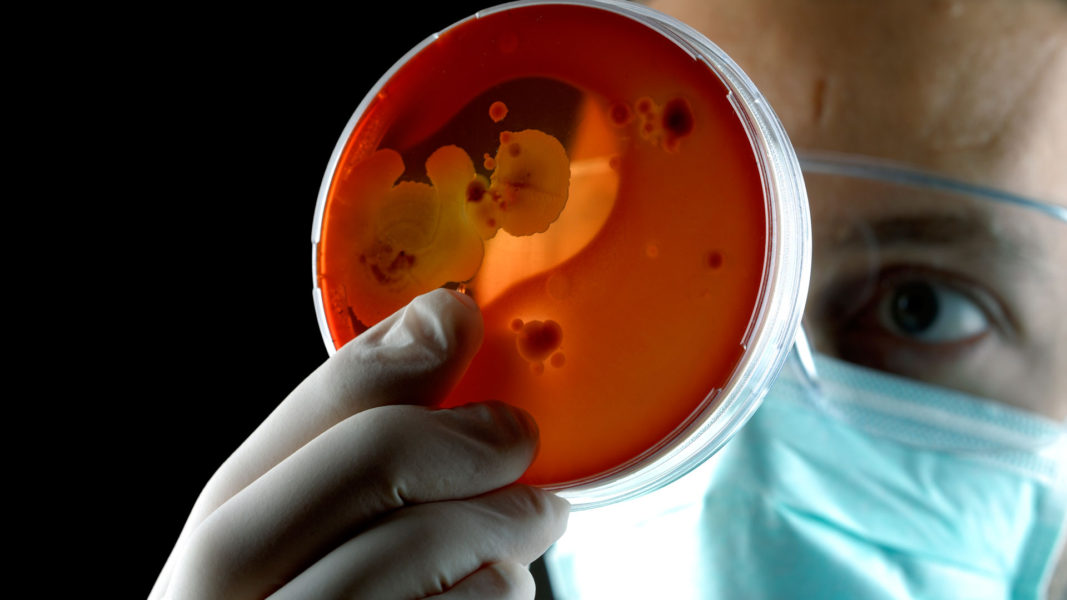

El 6 de octubre
de 1821 el almirante inglés Lord Thomas Alexander Cochrane (1775-1860), jefe de
la flota que había traslado el año anterior al Virreinato del Perú al Ejército Expedicionario
del general José de San Martín, sublevó la escuadra, que tenía bandera de
Chile, argumentando el atraso en el pago de sus servicios, y se la llevó rumbo
norte. La traición de Cochrane fue un severo golpe a la causa de la
independencia y debilitó al gobierno de San Martín como Protector de la Libertad del Perú.
Después de merodear con su flota por las costas de
México y otros territorios hispanoamericanos del Pacifico, atacando barcos y
guarniciones españolas, Cochrane volvió a Chile en junio de 1822, donde trató
de indisponer a su gobierno con San Martín. Fracasado en sus propósitos, se
puso a las órdenes de Pedro I de Brasil, que contrataba oficiales y soldados
desmovilizados de las guerras napoleónicas. Además de dirigir la escuadra
imperial brasileña en operaciones contra los portugueses, el almirante británico
también reprimió a los republicanos de la Confederación del Ecuador, formada en
Pernambuco en 1824, sublevados contra el absolutismo de los Braganza, por lo
que fue gratificado con el título de marqués de Maranhao. Luego estuvo en
Grecia entre 1827 y 1828, con los independentistas que luchaban contra el
imperio otomano, para después dejar sus aventuras, al servicio del mejor
postor, para regresar a su tierra natal.
Nacido en Escocia en 1775 en una familia arruinada de
la nobleza, a los doce años se había enrolado como tripulante en la marina de
guerra británica, donde tuvo una carrera meteórica y ganó cierta notoriedad. Se
distinguió en las guerras napoleónicas y llegó a capitán de la armada real y a
tener un escaño en la cámara de los lores. Acusado de un mega fraude en la
bolsa de valores de Londres, fue expulsado en 1817 de la marina y el parlamento,
despojado de condecoraciones, títulos e incluso condenado a prisión. Liberado,
puso un aviso en un periódico para conseguir trabajo, anuncio que leyó un
representante de San Martín, que lo contrató junto a otros oficiales y marineros
británicos.
Al
año siguiente, fue recibido por el Director Supremo de Chile, Bernardo
O´Higgins, quien organizaba junto con San Martín la campaña para la liberación
del Perú, recibiendo el grado de vicealmirante de la naciente flota nacional y
la ciudadanía chilena. Además de contribuir a la ocupación de la base naval
española más poderosa del Pacífico en Valdivia, el 3 de febrero de 1820, la escuadra de Cochrane transportó
unos meses después al ejército de San Martín al Perú. En El Callao encerró a la
flota enemiga y en sorpresivo combate naval se apoderó de la fragata Esmeralda,
buque insignia de la marina española.
Pero Cochrane no era un patriota
desinteresado, sino un mercenario obsesionado por recuperar su fortuna, por lo
que cada vez que se apoderaba de una embarcación exigía su botín como si fuera
un simple corsario, lo que San Martín no admitió. El tema fue enturbiando la
relación entre los dos jefes militares, sobre todo desde agosto de 1821, cuando
la situación hizo crisis al apoderarse sin autorización de recursos públicos
del gobierno que estaban en una goleta anclada en Ancón. Indignado por el robo,
San Martín le ordenó el 15 de septiembre que “restituya, a bordo de los
respectivos buques, las propiedades que han sido tomadas de ellos por
pertenecer, las más, al gobierno y las otras a los particulares que se hallan
bajo mi protección.” Distanciados por el grave incidente, el almirante inglés,
declarado en rebeldía, zarpó con la escuadra bajo su mando integrada por dos
fragatas, una de ellas la propia Esmeralda,
una corbeta, un bergantín y una goleta, lo que mereció el lapidario comentario
de San Martín: “Este Lord metálico, cuya conducta
puede compararse al más famoso filibustero”.
En 1828, enriquecido y de regreso en Londres,
recibió cuatro años después el perdón de la reina Victoria por el fraude cometido
y se le permitió heredar el título de conde de Dundonald y recibir el rango
honorífico de contraalmirante de la marina real. Al morir con 85 años de edad
fue enterrado con honores en la Abadía de Westminster
y sobre su tumba se puso la inscripción “Libertador
de Chile y Perú”. Quizás, como anota el historiador argentino Norberto
Galasso en su biografía de San Martín Seamos
Libres y lo demás no importa nada (2009), en reconocimiento al mercenario
inescrupuloso que contribuyó a la expansión del imperio británico.
Adenda
Sirvan estas líneas para despedirme de
los queridos lectores de la revista digital Informe Fracto y, en particular, de
su sección Madre América, que invoca el nombre de un texto paradigmático de
José Martí. Quiero agradecer en especial al doctor Carlos E. Bojórquez Urzaiz
por la oportunidad brindada, desde abril de 2019, para colaborar en esta
aventura del periodismo mediático, que me ha abierto nuevos horizontes. La
publicación de más de doscientas cincuenta notas cortas, dos semanales, sobre
temas desconocidos, insólitos o mal contados de la historia de América Latina,
fue un verdadero desafío. No sólo para mantener una entrega regular y puntual,
sino también conseguir que atrajeran a un público amplio y exigente, que de una
ojeada pudiera leerlas en sus celulares. Gracias a Informe Fracto, y su
excelente equipo editorial, algunas de esas notas aparecen en sendos libros
publicados en Chile, lo que reconoceré siempre.
Sergio Guerra Vilaboy